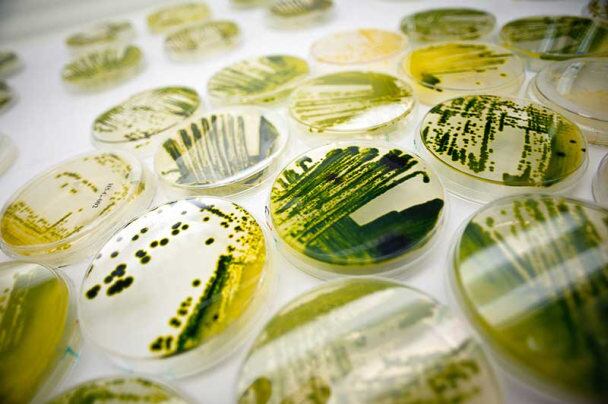

You don’t change the food system overnight, says CEO Jonathan Wolfson, who has been trying to translate all that promise into cold hard cash for almost 14 years, although the strategic decision to focus exclusively on food, feed and personal care (rather than biofuel/industrial products) was only made in 2016.
But TerraVia’s portfolio is undeniably disruptive, and leading food and beverage companies are finally sitting up and taking notice, he told FoodNavigator-USA at the IFT show in Chicago last month.
Video not loading? Watch it on YouTube instead!
Thrive Culinary Algae Oil could be a very large consumer brand
We began by asking whether Thrive Culinary Algae Oil, TerraVia’s first consumer brand in the food arena, was chiefly designed as a sideline to demonstrate to prospective b2b customers that people are OK with eating algae, or whether it could be a significant consumer brand in its own right?
There’s no doubt that having a consumer-facing brand helps to bring industrial ingredients to life, said Wolfson, but after a successful launch on the west coast, it quickly became clear that Thrive was doing more than that.
“With Thrive, we really had two missions. One was to animate algae food for people so they could really grasp it. The number of times we’ve walked into a room with chefs and started to talk about algae oil and they didn’t quite get it, and then we could pull out a bottle of Thrive, that’s actually selling in stores down the street ,and let them take it home and cook with, and all of a sudden lightbulbs go off…
“But we also believe Thrive has the opportunity to be a very large brand [in its own right]. We’ve only been in the market for eight or nine months and we’ve see very rapid acceptance; we had a phenomenal test market in southern California that’s now expanded to about four to five retailers and we’re going to be announcing some larger retailers soon. If you look on Amazon, it’s a five star product and people really love it.”

The mother of all plants
Consumers, he said, are not put off by ‘algae’ on a food label. Quite the opposite “We’ve done a whole lot of consumer work with respect to algae. With no education we’ve seen a better than 50% rate of acceptance and with just one or two sentences of education you get up into the 90s, so that now you have companies advertising algae on the label as a pull.”
The weird thing about algae is that it is both incredibly-old, and completely new, he said. And while it can be hard to weave a farm to fork style marketing story around something that is grown indoors in big fermenters, Thrive's success shows consumers are comfortable with it.
“You explain that algae is the mother of all plants; it’s earth’s original superfood and it’s always been there at the base of our food chain; we’ve just found a way to bring it to people.”

AlgaVia powders and AlgaWise oils
TerraVia's algae ingredients – whole algae lipid powers, protein powders under the AlaVia brand, and high-oleic oils under the AlgaWise brand – meanwhile, are now “in about 10 aisles of the grocery store today,” he said.
“We’re not in 100s of products yet, but we’re certainly in many dozens, and some of them actually are pretty high volume … the number of products from big food companies that are coming in at a later stage now is really exciting to me.
“The lipid powder is truly unique cos of its ability to replace things like eggs and butter… but it also has its barrier to entry as people have to find out how to use it, whereas with the proteins and oils, people [immediately] understand how to use them.”

Algae ‘butter’
Algae ‘butter’ meanwhile, which will hit the market shortly, is also a more straightforward ingredient to sell as a replacement for cocoa butter or shea butter in applications where certain properties (melting profiles etc) are required, he said, while TerraVia is also able customize its hard fats in order to meet specific technical requirements for different applications or customers, he added.
Changing the food system
As for changing the food system, something every self-respecting food/tech start-up apparently wants to do these days, TerraVia acknowledged the success of Hampton Creek, which could just have been another egg replacement firm, but has an almost cult-like following because it positioned itself as a mission-driven company intent on changing the food system.
However, TerraVia - which is also based in San Francisco - is in slightly different territory because it is developing completely new-to-the world ingredients, he argued.
“When you talk about changing the food system, I think about a table with four legs:
“We’re feeding more people with the same land and we can make more oil per hectare and more protein per hectare than any other plants out there. Then you look at environmental impact, so for example we can make oil with a lower carbon impact than any oil out there.
“The third leg is nutrition, our oil is completely disruptive and our powders are much healthier than what they are replacing. The fourth leg is economic accessibility, and that’s what spending the last almost 14 years on building the manufacturing has enabled; you can get cost in use improvements using our products.
“And sitting on the table top is amazing taste and texture.”